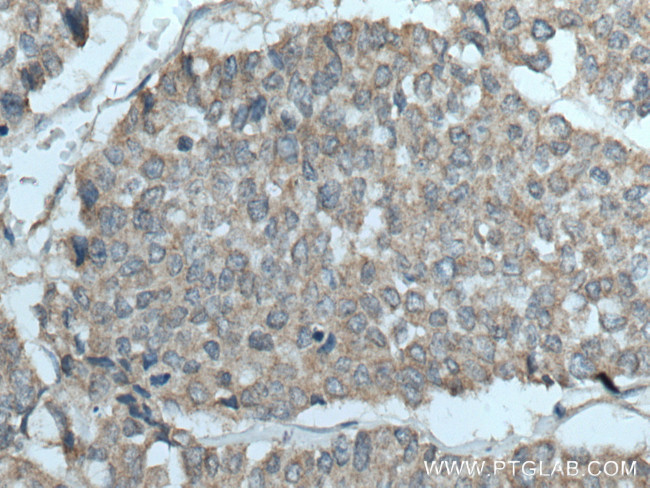
YWHAB Antibody in Immunohistochemistry (Paraffin) (IHC (P))

Search
Proteintech
YWHAB Polyclonal Antibody
{{$productOrderCtrl.translations['antibody.pdp.commerceCard.promotion.promotions']}}
{{$productOrderCtrl.translations['antibody.pdp.commerceCard.promotion.viewpromo']}}
{{$productOrderCtrl.translations['antibody.pdp.commerceCard.promotion.promocode']}}: {{promo.promoCode}} {{promo.promoTitle}} {{promo.promoDescription}}. {{$productOrderCtrl.translations['antibody.pdp.commerceCard.promotion.learnmore']}}
产品信息
10936-1-AP
种属反应
宿主/亚型
分类
类型
抗原
偶联物
形式
浓度
规格
纯化类型
保存液
内含物
保存条件
运输条件
产品详细信息
This antibody was raised against the N-terminal region of human YWHAB.
Immunogen sequence: MNDLICFLD NTFKNNVLSQ AWWCVHLVPT IWEAEAGGSL EPRSLKLQCP VVAPVNNCTP AWAT (1-63 aa encoded by BC010352)
靶标信息
14-3-3, a family of acidic and soluble proteins, highly conserved in amino acid sequences from yeast to mammals, is expressed in all eukaryotic cells. Seven isoforms(beta, gamma, epsilon, eta, zeta, sigma and tau/theta) encoded by seven distinct genes are identified in mammals and forms homo- and hetero- dimeric cup-shaped structures. As 14-3-3 is interacted with more than 100 binding partners, it regulates key proteins involved in various biological processes such as signal trans-duction, cell cycle, transcriptional control, cell proliferation, apoptosis, and ion channel physiology. Most 14-3-3 requires phosphorylation of serine or threonine residues in the target sequence. This protein is abundantly expressed in the brain and has been detected in the cerebrospinal fluid of patients with different neurological disorders.
仅用于科研。不用于诊断过程。未经明确授权不得转售。
篇参考文献 (0)
生物信息学
蛋白别名: 14-3-3 alpha; 14-3-3 alpha/beta; 14-3-3 protein beta; 14-3-3 protein beta-subtype; 14-3-3 protein beta/alpha; 3-monooxygenase/tryptophan 5 monooxygenase activation protein beta polypeptide; epididymis secretory protein Li 1; HS1; KCIP 1; KCIP-1; KCIP1; Prepronerve growth factor RNH-1; Protein 1054; Protein kinase C inhibitor protein 1; protein kinase C inhibitor protein-1; RP1-148E22.1; tryosine 3-monooxygenase/tryptophan 5-monooxygenase activation protein beta polypeptide; tryosine 3-monooxygenase/tryptophan 5-monooxygenase activation protein gamma; tyrosine 3-monooxgenase/tryptophan 5 monooxgenase activation protein beta polypeptide; tyrosine 3-monooxgenase/tryptophan 5 monooxgenase activation protein, beta polypeptide; tyrosine 3-monooxgenase/tryptophan 5-monooxgenase activation protein, beta polypeptide; tyrosine 3-monooxygenase/tryptophan 5-monooxygenase activation protein, alpha polypeptide; tyrosine 3-monooxygenase/tryptophan 5-monooxygenase activation protein, beta polypeptide; tyrosine 3/tryptophan 5 -monooxygenase activation protein beta polypeptide; tyrosine 3/tryptophan 5 -monooxygenase activation protein, beta polypeptide; unnamed protein product
基因别名: 1300003C17Rik; GW128; HEL-S-1; HS1; KCIP-1; YWHAA; YWHAB
UniProt ID: (Human) P31946, (Mouse) Q9CQV8, (Rat) P35213
Entrez Gene ID: (Human) 7529, (Mouse) 54401, (Rat) 56011